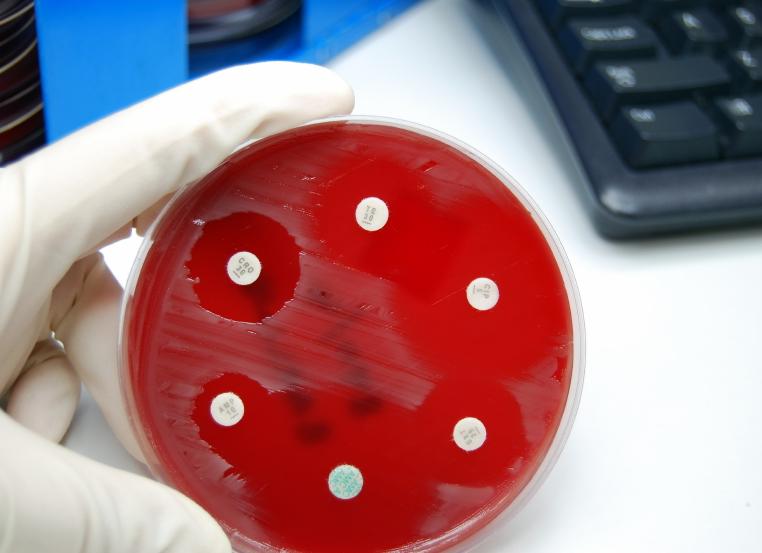
Бак посев на микрофлору и чувствительность к антибиотикам мочи

[Бак посев на микрофлору и чувствительность к антибиотикам мочи]
[Бак посев на микрофлору и чувствительность к антибиотикам мочи]
Бак посев мочи на флору и чувствительность к антибиотикам
x
Check Also
Патологии фаллопиевых труб как причина бесплодия Бесплодие является далеко не такой редкой проблемой, как может …
Самопроизвольный аборт: лечение и симптомы | Как остановить самопроизвольный аборт Cамопроизвольный аборт наиболее часто происходит …
Можно ли навсегда вылечить молочницу? Все больше женщин задается вопросом, можно ли вылечить молочницу, причем …
Если месячные не заканчиваются, что делать Менструация — ежемесячное явление, которое происходит у каждой женщины …
Грибок на ногах Грибок на ногах – это болезнь инфекционного характера, которую провоцируют болезнетворные грибы. …
Все о критических днях у женщин: полное досье и даже больше Народные приметы о критических …
Боли во время месячных: как можно избавиться от недуга? «Ну, вот опять, эти критические дни …
Боровая матка для зачатия как принимать Боровую матку, которую еще называют ортилией однобокой, используют для …
Трубное бесплодие Специалисты нашей клиники неоднократно решали эту проблему у наших пациентов. Оплодотворение в естественных …
Женский сайт о красоте и отношениях Здоровье, отношения, диеты, дети, магия, семья и другие самые …
Прием дюфастона для вызова месячных: как и когда пить таблетки? Если бы у женщины была …
Мазок на флору у женщин: что по нему определяют, норма и патология Мазок на флору …
Внутриматочная спираль: все, что вам нужно знать о контрацептиве Одним из наиболее распространенных и эффективных …
Причины и лечение зуда в паху Механизм развития зуда в паху В большинстве случаев развитие …
Процедура вакуумной чистки матки: причины и осложнения Чтобы освободить полость матки от сгустков крови или …
Молочница у женщин Молочница у женщин – это грибковая инфекция наружных половых органов, получившая свое …
Таблетки “Викасол” для остановки месячных: отзывы, особенности применения и побочные действия Лекарственное средство «Викасол» является …
Грибок на ногах – фото, крема, чем лечить Грибок на ногах – частая проблема, которая …
Как поддержать девочку при первых месячных Современные подростки уже к моменту полового созревания хорошо осведомлены, …
Каковы причины появления белых выделений с зудом у женщин из влагалища В качестве основных показателей …
Болит живот после овуляции – о чем может говорить боль? Можно ли самостоятельно избавиться от …
Розовые выделения у женщин, причины выделений розового цвета Выделения у девушек, как правило, начинаются за …
Сгустки крови, похожие на печень при месячных: почему они появляются? Менструальный цикл, самочувствие во время …
Кровянистые выделения в середине цикла Едва заметные кровянистые выделения, слегка пачкающие прокладку, белье или оставляющие …
Бак посев мочи на флору и чувствительность к антибиотикам
Бактериологическое исследование мочи – сложный лабораторный анализ, который характеризуется высокоточной информативностью. Позволяет выявить в урине патогенные микроорганизмы, не определяемые с помощью общего анализа мочи. Биоматериал на исследования сдают по назначению врача в случае подозрений на присутствие инфекции мочевых путей и органов выделительной системы.
Что такое анализ мочи на бак посев? Данный метод исследования выявляет и определяет тип вредоносных микробов, вызывающих инфекции и воспаления, на основе чего делаются выводы об общем состоянии здоровья. Кроме того, посев мочи на микрофлору определяет чувствительность микроорганизмов к антибиотикам и фагам (бактериофаг – вирус, пожирающий бактерии).
В норме урина не должна быть полностью стерильной, допускается присутствие незначительного числа бактерий. При обнаружении микроорганизмов (бактериурии) можно говорить о возможном воспалении в одном из отделов мочевыделительной системы. Бактериальный посев мочи точно показывает, сколько патогенных и условно-патогенных микроорганизмов присутствует в моче. По их количеству делаются предположения о степени тяжести инфекционного процесса.
Какие микробы обычно обнаруживает бакпосев мочи у взрослого человека? Зачастую в биоматериале определяются стрептококки, дефтероиды, стафилококки, клебсиелла (klebsiella pneumoniae), грибы. Эти микроорганизмы представляют опасность, если их количество значительно превышает допустимые показатели.
Показания к назначению бак анализа
Бак посев мочи не назначается в профилактических целях. В этом нет смысла, так как микрофлора у каждого человека индивидуальна, и условно-патогенные бактерии могут жить, не причиняя вреда здоровью. Анализ мочи на посев проводят, если подозревают инфекционное поражение мочевыделительного тракта. Мочу на посев сдают и в ситуациях, когда ОАМ или анализ мочи по Ничепоренко показывает какие-либо отклонения от нормы. Этот вид исследования назначается в основном по следующим показаниям:
- Боли режущего характера во время мочеиспускания (наблюдаются при цистите).
- Болезненность поясничного отдела (косвенное доказательство того, что бактерии размножаются в почечных канальцах).
- Общая слабость, тошнота, рвота, повышение температуры – симптомы, указывающие на патогенную флору в почках (при пиелонефрите).
- Дизурия – нарушенная частота мочеиспусканий. Слишком частые либо слишком редкие походы в туалет могут свидетельствовать о поражении почек. При простатите также возможна дизурия.
- Контроль эффективности терапии. Если диагноз известен и назначена антибактериальная терапия, то посев мочи на флору у больного позволяет своевременно среагировать на изменения эффективности назначенных препаратов.
- Контроль беременности, имеющий профилактический характер. В период вынашивания плода женщине приходится дважды выполнять сбор мочи на бактериологическое исследование, поскольку в 3–10 % случаев наблюдается скрытая бактериурия.
- Болезни органов ЖКТ (энтерококк и дизентерия).
- Также регулярно сбор мочи делается при сахарном диабете и у ВИЧ-позитивных пациентов.
Методика исследования
Анализ мочи на бак посев подразумевает определенный алгоритм стандартных действий:
- проводится первичное микроскопическое исследование осадка мочевой жидкости (согласно показаниям этот пункт может быть пропущен),
- затем – первичный посев мочи на стерильность для определения типа возбудителя,
- далее собранную в посеве культуру накапливают,
- изучают особенности выделенных микроорганизмов,
- готовый результат исследования – окончательная идентификация возбудителя.
Изучение мочи на бакпосев подразумевает подбор нужной среды для конкретного микроорганизма. К примеру, высевание стафилококка происходит в кровяном агаре, стрептококков – в сахарном растворе, грибов – в среде Сабуро. Допускается проведение посева сразу в нескольких средах (наибольшее число 3–4).
Сколько времени требуется для проведения этого анализа? После того, как сдается моча, результаты посева начинают исследоваться уже со второго дня. Окончательное заключение касательно идентификации возбудителя будет получено спустя 7–10 дней. Алгоритм изучения результатов подразумевает описание:
- величины,
- формы,
- прозрачности,
- оттенка,
- структуры поверхности,
- роста колонии в высоту (вдавленная либо плоская).
Особенности бакпосева на антибиотикограмму
Анализ на флору с определением чувствительности к антибиотикам помогает подобрать максимально эффективное лечение. Полученный результат называется антибиотикограмма. Бактериологический анализ мочи на флору и чувствительность к антибиотикам имеет следующий алгоритм действий:
- Чаша Петри делится на зоны, в каждую из которых помещают полоску с антибиотиком. Их маркируют по цвету.
- Зоны засеваются выделенной культурой.
- Помещают чашу в термостат с температурой 36,6.
- Каждый день контролируют ситуацию.
Подходящий антибиотик полностью уничтожает бактерии, не давая им возможности размножаться. Если же микроорганизмы отличаются устойчивостью, значит, антибактериальное средство не может использоваться в терапии.
Сколько времени требуется на то, чтобы был проведен анализ? Посев мочи длится 7–10 дней. Результат современных экспресс-методов готовится за два дня. При этом предоставляется информация не только относительно чувствительности к препаратам, но также определяется их дозировка в терапии. При необходимости срочно получить результаты, например, для экстренного лечения тяжелого больного, в условиях стационара могут быть предоставлены предварительные сведения уже спустя 4 часа.
Как сдавать посев мочи правильно?
Чтобы получить максимально корректные результаты анализа, важно соблюдать некоторые правила. За 12–14 часов до того, как будет проведен забор материала, не рекомендуется употреблять большое количество жидкости. В противном случае число бактерий в моче будет снижено. Также подготовка пациента подразумевает исключение алкогольных напитков за неделю до анализа.
Согласно правилам, для анализа сдается утренняя моча, однако в экстренных случаях допустимо собрать образец посреди дня. При этом нельзя опорожняться минимум за несколько часов до сдачи мочи. Женщинам запрещается спринцеваться.
Важно правильно подготовиться к сдаче материала. Стоит предварительно вымыть половые органы и руки, чтобы предотвратить попадание в урину микробов извне. В противном случае бактериологический посев мочи может дать ложные результаты. Собирать мочу необходимо не всю, а именно среднюю порцию.
Для хранения и доставки материала должна использоваться стерильная баночка или специальный контейнер. Правильно сдавать именно свежесобранный образец, поскольку урина хранится не более 2 часов. Поэтому нужно доставить ее в лабораторию сразу после забора.
Взятие мочи на бактериологическое исследование не рекомендовано, если менее чем за две недели до этого принимались антибиотики. Также влияние на результаты могут оказать мочегонные средства, поэтому сдавать урину на анализ на фоне их приема также противопоказано.
Расшифровка результатов
Измеряется количество бактерий в КОЕ (колониеобразующих единицах) на 1 мл урины. Чем выше КОЕ, тем шире условно-патогенная и патогенная микрофлора. Расшифровать результаты может каждый, однако этого мало – необходима их правильная интерпретация. Многие пациенты пытаются сделать это самостоятельно, но только лечащий врач может дать точную оценку проведенного исследования.
Норма бактерий должна быть в количестве не более 1000 КОЕ/мл. Также не должен вызывать подозрений отрицательный результат. Если анализ показал от 10 до 1000 КОЕ, можно предположить, что был произведен неправильный сбор урины. Поэтому необходимо будет сдавать анализ мочи повторно.
Показатели КОЕ соответствуют тому или иному заболеванию. Например, при цистите значение имеет отметка всего лишь в 100 КОЕ, при пиелонефрите – 10000 КОЕ. Если же показатель очень велик – свыше 100 000 КОЕ, значит, в мочевыделительной системе происходит сильный воспалительный процесс, и необходимо срочно назначать лечение. Например, большое количество КОЕ наблюдается, если возбудителем выступает клебсиелла.
Бак посев урины у детей
Показания для проведения бак посева в детском возрасте такие же, как и у взрослых. Нередко у детей первого года жизни наблюдается дисбактериоз кишечника, который вызывает клебсиелла. Из-за несовершенства иммунной системы эта бактерия быстро размножается. Клебсиеллезная инфекция определяется при помощи посева урины на флору, бактериоскопии, серологических методов.
Как сдавать бак посев мочи в детском возрасте? Чтобы получить максимально точные результаты, следует правильно собрать мочу. Для анализа подходит лишь утренняя урина, в то время как у новорожденных подойдет любая, какую только удастся получить. Как собрать мочу на бакпосев у ребенка? У грудничка провести забор мочи можно с помощью специальных полиэтиленовых мочесборников.
Детям постарше нужно предложить помочиться сначала в унитаз, чтобы выпустить первую порцию урины. Затем среднюю часть мочи собрать в стерильный контейнер и в короткие сроки доставить в лабораторию. Для проведения анализа берется около 10 мл урины – этого достаточно для определения имеющихся микроорганизмов.
Правила сбора образца у ребенка предполагают прекращение приема антибиотиков. Поэтому родители должны вовремя предупредить об этом врача, который впоследствии будет расшифровывать результаты.
(Пока оценок нет) Загрузка…
Бак посев мочи на флору и чувствительность к антибиотикам
Суть бактериологического посева
Показания к назначению бак анализа
- Боли режущего характера во время мочеиспускания (наблюдаются при цистите).
- Болезненность поясничного отдела (косвенное доказательство того, что бактерии размножаются в почечных канальцах).
- Общая слабость, тошнота, рвота, повышение температуры – симптомы, указывающие на патогенную флору в почках (при пиелонефрите).
- Дизурия – нарушенная частота мочеиспусканий. Слишком частые либо слишком редкие походы в туалет могут свидетельствовать о поражении почек. При простатите также возможна дизурия.
- Контроль эффективности терапии. Если диагноз известен и назначена антибактериальная терапия, то посев мочи на флору у больного позволяет своевременно среагировать на изменения эффективности назначенных препаратов.
- Контроль беременности, имеющий профилактический характер. В период вынашивания плода женщине приходится дважды выполнять сбор мочи на бактериологическое исследование, поскольку в 3–10 % случаев наблюдается скрытая бактериурия.
- Болезни органов ЖКТ (энтерококк и дизентерия).
- Также регулярно сбор мочи делается при сахарном диабете и у ВИЧ-позитивных пациентов.
Методика исследования
- проводится первичное микроскопическое исследование осадка мочевой жидкости (согласно показаниям этот пункт может быть пропущен);
- затем – первичный посев мочи на стерильность для определения типа возбудителя;
- далее собранную в посеве культуру накапливают;
- изучают особенности выделенных микроорганизмов;
- готовый результат исследования – окончательная идентификация возбудителя.
- величины;
- формы;
- прозрачности;
- оттенка;
- структуры поверхности;
- роста колонии в высоту (вдавленная либо плоская).
Особенности бакпосева на антибиотикограмму
- Чаша Петри делится на зоны, в каждую из которых помещают полоску с антибиотиком. Их маркируют по цвету.
- Зоны засеваются выделенной культурой.
- Помещают чашу в термостат с температурой 36,6.
- Каждый день контролируют ситуацию.
Как сдавать посев мочи правильно?
Расшифровка результатов
Бак посев урины у детей
Получай уведомления о новых материалах на нашем сайте
Бак посев мочи на флору и чувствительность к антибиотикам
x
Check Also
Что такое РДВ в гинекологии Многие женщины, узнав от своего врача о необходимости процедуры, которая …
Нежелательная беременность на ранних сроках народными средствами Как прервать беременность народными средствами Беременность – Божий …
Безопасный аборт? Планирование и ведение простой и осложненной беременности После родов нередко молодые мамы, ориентируясь …
Предотвращение беременности на ранних сроках: что можно сделать? Врачи единодушны: о контрацепции необходимо думать заранее. …
Дицинон при месячных Дицинон при месячных – препарат, позволяющий женщинам избавиться от долгих и обильных …
Что лучше: тампоны или прокладки? Домашние обязанности в нашей семье были распределены следующим образом: я …
Невынашивание беременности Невынашивание беременности — одна из серьезных проблем современного акушерства, частота которой составляет 10—25 …
Таблетки для прерывания беременности Пожалуй, каждый человек, у которого Вы спросите, как он относится к …
Моя беременность от самых первых дней беременности до школы Последние записи Популярные статьи Рассказы о …
Сбой месячных: причины нарушений цикла Регулярный месячный цикл – основа женского репродуктивного здоровья. Однако его …
Лечение сухости влагалища Сухость во влагалище – это состояние, когда в слизистой оболочке наружных половых …
Белые густые выделения без запаха. Заболевание ли это Иногда женщина обеспокоена тем, что у нее …
Почему после отмены противозачаточных нет месячных? Противозачаточные препараты помогают женщине предохраняться от нежелательной беременности. Естественный …
Месяц нет месячных, но нет и беременности – о чем это говорит? Узнайте, по каким …